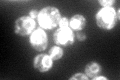
YML012W
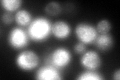
YML012W
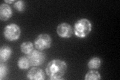
YML012W

View description
Protein that forms a heterotrimeric complex with Erp1, Erp2p, and Emp24, member of the p24 family involved in endoplasmic reticulum to Golgi transport
Localization:
Intensity:
Fold change:
Significance:
-
C’ GFP library in SD
ER122.29 -
N' NOP1pr-GFP in SD

punctate,vacuole84.9925 -
N' TEF2pr-mCherry in SD

vacuole44.7096 -
N' NATIVEpr-GFP in SD

punctate82.7184 -
N' TEF2pr-VC and Cyto-VN in SD

#N/A0 -
C’ GFP library in SD+DTT
ER167.321.36No -
C’ GFP library in SD+H2O2

ER130.231.06No -
C’ GFP library in Starvation Media
ER120.820.98No -
C’ GFP library on the background of Pup2-DaMP

ER -
C’ GFP library on the background of CCT mutant

ER123.3911.00895No
